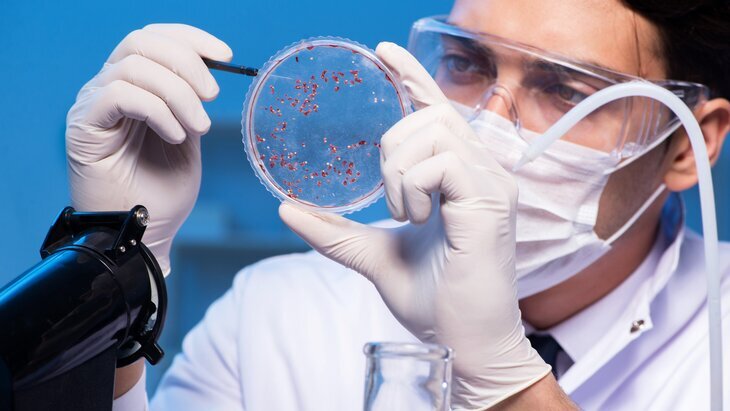

Китайские ученые: черника профилактирует сердечно-сосудистые заболевания

Фото: 123RF/dariafomina
Черника полезна для снижения риска эндотелиальной дисфункции, которая известна как опасный фактор развития сердечно-сосудистых заболеваний. К такому выводу пришли ученые из Сычуаньского университета. При этом важно правильно выбирать ягоду, чтобы она не навредила.
Чем полезна черника
Китайские ученые провели мета-анализ 11 исследований, участниками которых стали 400 человек, и установили, что потребление черники значительно улучшает функции и здоровье сосудов. Кроме того, ягода снижает диастолическое артериальное давление.
Черника полезна не только для сердца, но и для сохранения когнитивных способностей в пожилом возрасте, целостности мышц, снижения риска развития преддиабета и диабета второго типа.
Такие результаты могут быть обусловлены высоким содержанием полифенолов в чернике. Это биологически активные соединения растительного происхождения, которые подавляют воспаление и защищают клетки от повреждения свободными радикалами. Результаты исследования опубликованы в журнале Frontiers in Psychology.
Фото: 123RF/Elnur
Как выбрать безопасную и полезную чернику
Как отличить хорошие ягоды
Черника должна иметь однородный темный цвет, быть крупной, с сухой ровной поверхностью. Сизый налет говорит о том, что ягоды собрали недавно, причем они не были перемешаны в разных емкостях. Мятой черники, загрязненной и излишне влажной лучше избегать.
Какие вредные вещества накапливает черника
Как и остальные растения своего семейства (брусника, голубика, клюква), черника накапливает радиоактивный цезий в количествах, превышающих нормативы, установленные техническим регламентом. Употребление такой ягоды не только не приносит пользу, но и увеличивает риск развития злокачественных новообразований у человека.
Где безопасно покупать свежую чернику
Черника может накапливать радиацию, поэтому стоит внимательно подходить к выбору места покупки ягод. Роспотребнадзор рекомендует приобретать продукт на официальном рынке или ярмарке. В местах стихийной торговли, вдоль автотрасс или у случайных продавцов могут быть опасные ягоды.
Как правильно собирать чернику
Сбором лучше заниматься в конце июня или начале июля. Делать это комфортнее утром или вечером. Ягода очень нежная и легко мнется, поэтому собирать лучше вручную. Избегайте мест около оживленных трасс или предприятий, где черника могла бы накопить вредные вещества из почвы.
Ранее эксперт рассказала, что свежие сезонные ягоды богаты витаминами и другими полезными веществами, которые улучшают работу сердца и сосудов, снимают воспаления, а также улучшают пищеварение.
Никитина Алена



















